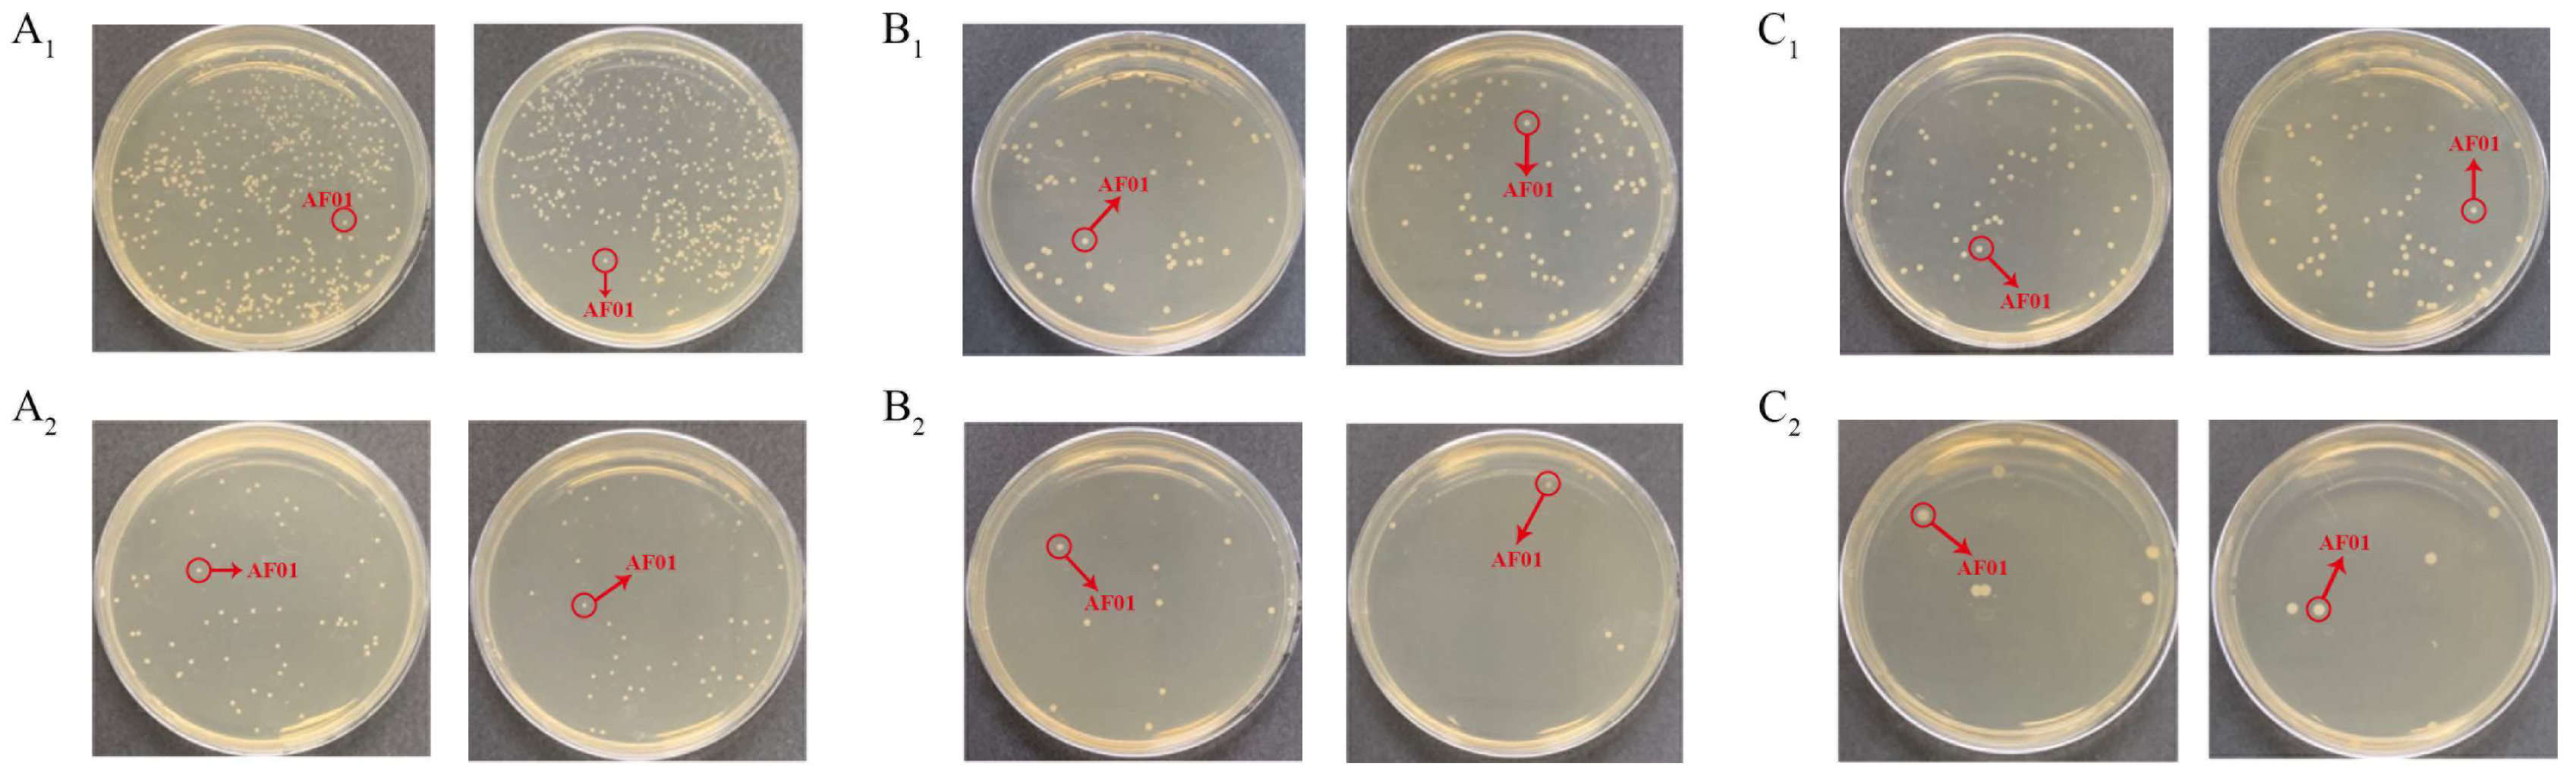

Bioremediation of Aflatoxin B1 by Meyerozyma guilliermondii AF01 in Peanut Meal via Solid-State Fermentation
Abstract
1. Introduction
2. Results and Discussion
2.1. Analysis of Single-Factor Experimental Results

2.2. Analysis of Response Surface Experiment Results
2.3. Analysis of the Removal Effect of Aflatoxins in Simulated Actual Production
2.4. The Effect of AF01 Strain Fermentation on the Nutrition of Peanut Meal
3. Conclusions
4. Materials and Methods
4.1. Chemicals and Regents
4.2. Preparation of AF01 Strain Seed Solution
4.3. Peanut Meal Preparation
4.4. AFB1 Detection Method
4.5. Single-Factor Experiments on Detoxification of Peanut Meal
4.6. Response Surface Experiment on Detoxification of Peanut Meal
4.7. Increased Detoxification in Trays and Fermentation Bags
4.8. Determination of the Nutritional Components of Peanut Meal before and after Fermentation
4.8.1. Phytic Acid Content Determination
4.8.2. Determination of Total Sugar Content
4.8.3. Amino Acid Composition Determination
4.9. Statistical Analysis
Supplementary Materials
Author Contributions
Funding
Institutional Review Board Statement
Informed Consent Statement
Data Availability Statement
Conflicts of Interest
References
- Zhao, T.; Ying, P.; Zhang, Y.; Chen, H.; Yang, X. Research advances in the high-value utilization of peanut meal resources and its hydrolysates: A review. Molecules 2023, 28, 6862. [Google Scholar] [CrossRef] [PubMed]
- Minougou, N.; Kabore, A.B.; Savadogo, M.; Dera, M.K.-S.; Dahourou, D.L. Assessing the prevalence of aflatoxin B1 in poultry feed in Dakar, Senegal: Implications for animal and public health. Int. J. Biol. Chem. Sci. 2024, 17, 2677–2688. [Google Scholar] [CrossRef]
- Pickova, D.; Ostry, V.; Toman, J.; Malir, F. Aflatoxins: History, significant milestones, recent data on their toxicity and ways to mitigation. Toxins 2021, 13, 399. [Google Scholar] [CrossRef] [PubMed]
- Renaud, J.B.; Walsh, J.P.; Sumarah, M.W. Simplified synthesis and stability assessment of aflatoxin B1-Lysine and aflatoxin G1-Lysine. Toxins 2022, 14, 56. [Google Scholar] [CrossRef] [PubMed]
- Ivanovics, B.; Gazsi, G.; Reining, M.; Berta, I.; Poliska, S.; Toth, M.; Domokos, A.; Nagy, B., Jr.; Staszny, A.; Cserhati, M.; et al. Embryonic exposure to low concentrations of aflatoxin B1 triggers global transcriptomic changes, defective yolk lipid mobilization, abnormal gastrointestinal tract development and inflammation in zebrafish. J. Hazard. Mater. 2021, 416, 125788. [Google Scholar] [CrossRef] [PubMed]
- Park, S.; Lee, J.-Y.; You, S.; Song, G.; Lim, W. Neurotoxic effects of aflatoxin B1 on human astrocytes in vitro and on glial cell development in zebrafish in vivo. J. Hazard. Mater. 2020, 386, 121639. [Google Scholar] [CrossRef]
- Chen, X.; Abdallah, M.F.; Grootaert, C.; Nieuwerburgh, F.V.; Rajkovic, A. New insights into the combined toxicity of aflatoxin B1 and fumonisin B1 in HepG2 cells using Seahorse respirometry analysis and RNA transcriptome sequencing. Environ. Int. 2023, 175, 107945. [Google Scholar] [CrossRef]
- Schrenk, D.; Bignami, M.; Bodin, L.; Chipman, J.K.; Mazo, J.d.; Grasl-Kraupp, B.; Hoogenboom, L.; Leblanc, J.-C.; Nebbia, C.S.; Nielsen, E.; et al. Assessment of an application on a detoxification process of groundnut press cake for aflatoxins by ammoniation. EFSA J. 2021, 19, e07035. [Google Scholar] [CrossRef] [PubMed]
- Lou, H.; Li, Y.; Yang, C.; Li, Y.; Gao, Y.; Li, Y.; Zhao, R. Optimizing the degradation of aflatoxin B1 in corn by Trametes versicolor and improving the nutritional composition of corn. J. Sci. Food Agric. 2024, 104, 655–663. [Google Scholar] [CrossRef]
- Nogueira, W.V.; Moyano, F.J.; García, M.J.A.; Tesser, M.B.; Buffon, J.G. Preliminary assessment of bioaccessibility of aflatoxin B1 in fish. Aquac. Int. 2022, 30, 1315–1325. [Google Scholar] [CrossRef]
- Utama, G.L.; Suraloka, M.P.A.; Rialita, T.; Balia, R.L. Antifungal and aflatoxin-reducing activity of β-glucan isolated from Pichia norvegensis grown on tofu wastewater. Foods 2021, 10, 2619. [Google Scholar] [CrossRef]
- Hojati, M.; Norouzian, M.A.; Alamouti, A.A.; Afzalzadeh, A. In vitro evaluation of binding capacity of different binders to adsorb aflatoxin. Vet. Res. Forum 2021, 12, 211–214. [Google Scholar] [CrossRef] [PubMed]
- Ashry, A.; Taha, N.M.; Lebda, M.A.; Abdo, W.; El-Diasty, E.M.; Fadl, S.E.; Elkamshishi, M.M. Ameliorative effect of nanocurcumin and Saccharomyces cell wall alone and in combination against aflatoxicosis in broilers. BMC Vet. Res. 2022, 18, 178. [Google Scholar] [CrossRef]
- Zhang, Y.; Wang, P.; Kong, Q.; Cotty, P.J. Biotransformation of aflatoxin B1 by Lactobacillus helviticus FAM22155 in wheat bran by solid-state fermentation. Food Chem. 2021, 341, 128180. [Google Scholar] [CrossRef] [PubMed]
- Cai, M.; Qian, Y.; Chen, N.; Ling, T.; Wang, J.; Jiang, H.; Wang, X.; Qi, K.; Zhou, Y. Detoxification of aflatoxin B1 by Stenotrophomonas sp. CW117 and characterization the thermophilic degradation process. Environ. Pollut. 2020, 261, 114178. [Google Scholar] [CrossRef] [PubMed]
- Adegoke, T.V.; Yang, B.; Tian, X.; Yang, S.; Gao, Y.; Ma, J.; Wang, G.; Si, P.; Li, R.; Xing, F. Simultaneous degradation of aflatoxin B1 and zearalenone by Porin and Peroxiredoxin enzymes cloned from Acinetobacter nosocomialis Y1. J. Hazard. Mater. 2023, 459, 132105. [Google Scholar] [CrossRef] [PubMed]
- Jallow, A.; Xie, H.; Tang, X.; Zhang, Q.; Li, P. Worldwide aflatoxin contamination of agricultural products and foods: From occurrence to control. Compr. Rev. Food Sci. Food Saf. 2021, 20, 2332–2381. [Google Scholar] [CrossRef] [PubMed]
- Escriva, L.; Calpe, J.; Lafuente, C.; Moreno, A.; Musto, L.; Meca, G.; Luz, C. Aflatoxin B1 and ochratoxin A reduction by Lactobacillus spp. during bread making. J. Sci. Food Agric. 2023, 103, 7095–7103. [Google Scholar] [CrossRef]
- Li, S.; Li, C.; Chen, S.; Wang, X.; Liu, J.; Deng, X.; Liu, H.C. Effects of solid-state fermentation on the standardized ileal digestibility of amino acids and apparent metabolizable energy in peanut meal fed to broiler chickens. Fermentation 2023, 9, 346. [Google Scholar] [CrossRef]
- Zhang, W.; Wang, J.; Dou, J.; Li, T.; Liu, H.; Chang, X.; Qian, S.; Lv, L.; Wu, W.; Sun, C. A novel investigated method for decoupling adsorption and degradation effect on AFB1 based on isotope tracing and NMR analysis. Food Chem. 2023, 405, 134978. [Google Scholar] [CrossRef]
- Zhang, W.; Dou, J.; Wu, Z.; Li, Q.; Wang, S.; Xu, H.; Wu, W.; Sun, C. Application of non-aflatoxigenic Aspergillus flavus for the biological control of aflatoxin contamination in China. Toxins 2022, 14, 681. [Google Scholar] [CrossRef]
- Ma, Y.; Sun, C.; Wang, J.; Du, W.; Liu, H.; Zhou, W.; Zhao, Y. Screening, identification and degradation mechanism of T-2 toxin-degrading bacteria. Chin. J. Food Sci. 2023, 44, 173–182. [Google Scholar] [CrossRef]
- Jia, C.; Ou, X.; Wang, Y. Study on fermentation kinetics of a filamentous fungi roducing cellulase with facultative anerobic liquid-state type. J. Northeast Agric. Univ. 2011, 42, 123–129. [Google Scholar] [CrossRef]
- Zhao, D.; Xie, H.; Gao, L.; Zhang, J.; Li, Y.; Mao, G.; Zhang, H.; Wang, F.; Lam, S.S.; Song, A. Detoxication and bioconversion of aflatoxin B1 by yellow mealworms (Tenebrio molitor): A sustainable approach for valuable larval protein production from contaminated grain. Ecotoxicol. Environ. Saf. 2022, 242, 113935. [Google Scholar] [CrossRef]
- Jiang, T.; Li, F.; Li, F.; Xie, C.; Liu, D.; Yao, D. Degradation of aflatoxin B1 by the Armillariella tabescens-derived aldo-keto reductase AtAKR. Food Biosci. 2024, 58, 103768. [Google Scholar] [CrossRef]
- Murcia, H.W.; Diaz, G.J. In vitro hepatic aflatoxicol production is related to a higher resistance to aflatoxin B1 in poultry. Sci. Rep. 2020, 10, 5508. [Google Scholar] [CrossRef]
- Wang, Y.; Zhao, C.; Zhang, D.; Zhao, M.; Zheng, D.; Lyu, Y.; Cheng, W.; Guo, P.; Cui, Z. Effective degradation of aflatoxin B1 using a novel thermophilic microbial consortium TADC7. Bioresour. Technol. 2017, 224, 166–173. [Google Scholar] [CrossRef]
- Yu, Y.; Wu, H.; Tang, Y.; Qiu, L. Cloning, expression of a peroxiredoxin gene from Acinetobacter sp SM04 and characterization of its recombinant protein for zearalenone detoxification. Microbiol. Res. 2012, 167, 121–126. [Google Scholar] [CrossRef]
- Chelladurai, S.J.; Murugan, K.; Ray, A.P.; Upadhyaya, M.; Narasimharaj, V.; Gnanasekaran, S. Optimization of process parameters using response surface methodology: A review. In Proceedings of the International Conference on Newer Trends and Innovations in Mechanical Engineering (ICONTIME)—Materials Science, Electr Network, Tiruchirappalli, India, 15–16 October 2020; pp. 1301–1304. [Google Scholar]
- Ladaci, N.; Saadia, A.; Belaadi, A.; Boumaaza, M.; Chai, B.X.; Abdullah, M.M.S.; Al-Khawlani, A.; Ghernaout, D. ANN and RSM prediction of water uptake of recycled HDPE biocomposite reinforced with treated palm waste W. filifera. J. Nat. Fibers 2024, 21, 2356697. [Google Scholar] [CrossRef]
- Sena, V.D.; Mazzarella, G.; Rossi, M. Effects of transamidation vs. fermentation to reduce the gluten content of the Triticum monococcum wheat cultivar Hammurabi: Analysis of biochemical, baking and sensory parameters. Int. J. Food Sci. Technol. 2024, 59, 1927–1934. [Google Scholar] [CrossRef]
- Du, G.; Shi, J.; Zhang, J.; Ma, Z.; Liu, X.; Yuan, C.; Zhang, B.; Zhang, Z.; Harrison, M.D. Exogenous probiotics improve fermentation quality, microflora phenotypes, and trophic modes of fermented vegetable waste for animal feed. Microorganisms 2021, 9, 644. [Google Scholar] [CrossRef] [PubMed]
- Ying, W.; Zhu, R.; Lu, W.; Gong, L. A new strategy to apply Bacillus subtilis MA139 for the production of solid-state fermentation feed. Lett. Appl. Microbiol. 2009, 49, 229–234. [Google Scholar] [CrossRef] [PubMed]
- Puniya, A.K.; Salem, A.Z.M.; Kumar, S.; Dagar, S.S.; Griffith, G.W.; Puniya, M.; Ravella, S.R.; Kumar, N.; Dhewa, T.; Kumar, R. Role of live microbial feed supplements with reference to anaerobic fungi in ruminant productivity: A review. J. Integr. Agric. 2015, 14, 550–560. [Google Scholar] [CrossRef]
- Wang, C.; Qiu, X.; Hou, R.; Liu, J.; Li, L.; Mao, X. Improvement of soybean meal quality by one-step fermentation with mixed-culture based on protease activity. Innov. Food Sci. Emerg. Technol. 2023, 85, 103311. [Google Scholar] [CrossRef]
- Wang, X.; Qin, X.; Hao, Z.; Luo, H.; Yao, B.; Su, X. Degradation of four major mycotoxins by eight manganese peroxidases in presence of a dicarboxylic acid. Toxins 2019, 11, 566. [Google Scholar] [CrossRef] [PubMed]
- Shi, H.; Yang, E.; Li, Y.; Chen, X.; Zhang, J. Effect of solid-state fermentation on nutritional quality of leaf flour of the drumstick tree (Moringa oleifera Lam.). Front. Bioeng. Biotechnol. 2021, 9, 626628. [Google Scholar] [CrossRef] [PubMed]
- Cui, Y.; Li, J.; Deng, D.; Lu, H.; Tian, Z.; Liu, Z.; Ma, X. Solid-state fermentation by Aspergillus niger and Trichoderma koningii improves the quality of tea dregs for use as feed additives. PLoS ONE 2021, 16, e0260045. [Google Scholar] [CrossRef]
- Suprayogi, W.P.S.; Ratriyanto, A.; Akhirini, N.; Hadi, R.F.; Setyono, W.; Irawan, A. Changes in nutritional and antinutritional aspects of soybean meals by mechanical and solid-state fermentation treatments with Bacillus subtilis and Aspergillus oryzae. Bioresour. Technol. Rep. 2022, 17, 100925. [Google Scholar] [CrossRef]
- Cui, J.; Xia, P.; Zhang, L.; Hu, Y.; Xie, Q.; Xiang, H. A novel fermented soybean, inoculated with selected Bacillus, Lactobacillus and Hansenula strains, showed strong antioxidant and anti-fatigue potential activity. Food Chem. 2020, 333, 127527. [Google Scholar] [CrossRef]
- Tan, Y.X.; Mok, W.K.; Lee, J.; Kim, J.; Chen, W.N. Solid state fermentation of Brewers’ spent grains for improved nutritional profile using Bacillus subtilis WX-17. Fermentation 2019, 5, 52. [Google Scholar] [CrossRef]
- Chanprasartsuk, O.-o.; Prakitchaiwattana, C. Growth kinetics and fermentation properties of autochthonous yeasts in pineapple juice fermentation for starter culture development. Int. J. Food Microbiol. 2022, 371, 109636. [Google Scholar] [CrossRef] [PubMed]
- Tanguler, H.; Sener, S. Production of naturally flavoured and carbonated beverages using Williopsis saturnus yeast and cold fermentation process. Food Biosci. 2022, 48, 101750. [Google Scholar] [CrossRef]
- Rogowska-Wrzesinska, A.; Larsen, P.M.; Blomberg, A.; Görg, A.; Roepstorff, P.; Norbeck, J.; Fey, S.J. Comparison of the proteomes of three yeast wild type strains: CEN.PK2, FY1679 and W303. Int. J. Genom. 2001, 2, 207–225. [Google Scholar] [CrossRef] [PubMed]
- Xing, M.; Chen, Y.; Li, B.; Tian, S. Characterization of a short-chain dehydrogenase/reductase and its function in patulin biodegradation in apple juice. Food Chem. 2021, 348, 129046. [Google Scholar] [CrossRef] [PubMed]
- Mo, X.; Zhou, M.; Li, Y.; Yu, L.; Bai, H.; Shen, P.; Zhou, X.; Zhu, H.; Sun, H.; Bu, R.; et al. Safety assessment of a novel marine multi-stress-tolerant yeast Meyerozyma guilliermondii GXDK6 according to phenotype and whole genome-sequencing analysis. Food Sci. Hum. Wellness 2024, 13, 2048–2059. [Google Scholar] [CrossRef]
- Sun, S.; Wang, K.; Sun, L.; Cheng, B.; Qiao, S.; Dai, H.; Shi, W.; Ma, J.; Liu, H. Therapeutic manipulation of gut microbiota by polysaccharides of Wolfiporia cocos reveals the contribution of the gut fungi-induced PGE2 to alcoholic hepatic steatosis. Gut Microbes 2020, 12, 1830693. [Google Scholar] [CrossRef]
- GB.4789.15-2016; NHFPC. Food Microbiology Inspection—Mold and Yeast Counting. Standards Press of China: Beijing, China, 2016. Available online: http://down.foodmate.net/standard/sort/3/49843.html (accessed on 27 May 2024).

| Inoculation Quantity (%) | Initial Colony Density | 24 h | 48 h | 72 h |
|---|---|---|---|---|
| 1 | 6.65 | 8.68 | 9.13 | 9.24 |
| 5 | 7.34 | 9.51 | 9.72 | 9.81 |
| 10 | 7.62 | 9.48 | 9.73 | 9.74 |
| 20 | 7.88 | 9.38 | 9.11 | 9.49 |
| 30 | 8.02 | 8.81 | 9.11 | 9.21 |
| Experiment Number | A: Time (h) | B: Inoculation Quantity (%) | C: Temperature (°C) | Detoxification Ratio of AFB1 (%) |
|---|---|---|---|---|
| 1 | 48 | 1 | 30 | 44.17 |
| 2 | 96 | 1 | 30 | 55.15 |
| 3 | 48 | 10 | 30 | 50.59 |
| 4 | 96 | 10 | 30 | 52.80 |
| 5 | 48 | 5.5 | 20 | 42.86 |
| 6 | 96 | 5.5 | 20 | 50.58 |
| 7 | 48 | 5.5 | 40 | 41.39 |
| 8 | 96 | 5.5 | 40 | 38.91 |
| 9 | 72 | 1 | 20 | 49.57 |
| 10 | 72 | 10 | 20 | 44.89 |
| 11 | 72 | 1 | 40 | 40.62 |
| 12 | 72 | 10 | 40 | 45.56 |
| 13 | 72 | 5.5 | 30 | 68.30 |
| 14 | 72 | 5.5 | 30 | 67.53 |
| 15 | 72 | 5.5 | 30 | 67.75 |
| 16 | 72 | 5.5 | 30 | 70.53 |
| 17 | 72 | 5.5 | 30 | 67.89 |
| Variance Source | Sum of Squares | Degrees of Freedom | Mean Square | F Value | p-Value | Significance |
|---|---|---|---|---|---|---|
| Model | 1989.38 | 9 | 221.04 | 82.92 | <0.0001 | *** |
| A | 42.46 | 1 | 42.46 | 15.93 | 0.0052 | ** |
| B | 2.34 | 1 | 2.34 | 0.88 | 0.3796 | – |
| C | 57.35 | 1 | 57.35 | 21.52 | 0.0024 | ** |
| AB | 19.23 | 1 | 19.23 | 7.21 | 0.0313 | * |
| AC | 26.01 | 1 | 26.01 | 9.76 | 0.0168 | * |
| BC | 23.14 | 1 | 23.14 | 8.68 | 0.0215 | * |
| A2 | 398.08 | 1 | 398.08 | 149.34 | <0.0001 | *** |
| B2 | 269.36 | 1 | 269.36 | 101.05 | <0.0001 | *** |
| C2 | 978.03 | 1 | 978.03 | 366.91 | <0.0001 | *** |
| Residual | 18.66 | 7 | 2.67 | |||
| Lack of fit | 12.67 | 3 | 4.22 | 0.50 | 0.1712 | Not significant |
| Pure error | 5.99 | 4 | 1.50 | |||
| Core total | 2008.04 | 16 |
| Total Sugar Content (%) | Total Amount of Amino Acids (%) | Phytic Acid Content (%) | |
|---|---|---|---|
| Peanut meal in the control group | 35.27 ± 0.37 | 42.66 ± 0.25 | 1.47 ± 0.10 |
| Fermented peanut meal | 39.37 ± 0.64 | 47.05 ± 0.28 | 0.68 ± 0.12 |
| % Change | +4.10% | +4.39% | −0.79% |
| Amino Acid Name | Abbreviation | Amino Acid Content in Control Group (%) | Amino Acid Content in Experimental Group (%) | % Increase |
|---|---|---|---|---|
| Aspartate | Asp | 5.39 | 6.01 | 0.62 |
| Threonine | Thr | 1.37 | 1.46 | 0.09 |
| Serine | Ser | 2.34 | 2.62 | 0.28 |
| Glutamate | Glu | 9.04 | 9.94 | 0.90 |
| Glycine | Gly | 2.68 | 2.93 | 0.25 |
| Alanine | Ala | 1.95 | 2.16 | 0.21 |
| Cysteine | Cys | 0.42 | 0.47 | 0.05 |
| Valine | Val | 1.87 | 2.11 | 0.24 |
| Methionine | Met | 0.35 | 0.36 | 0.01 |
| Isoleucine | Ile | 1.49 | 1.69 | 0.20 |
| Leucine | Leu | 3.16 | 3.52 | 0.36 |
| Tyrosine | Tyr | 1.53 | 1.66 | 0.13 |
| Phenylalanine | Phe | 2.41 | 2.62 | 0.21 |
| Lysine | Lys | 1.5 | 1.71 | 0.21 |
| Histidine | His | 1.03 | 1.14 | 0.11 |
| Arginine | Arg | 4.97 | 5.19 | 0.22 |
| Proline | Pro | 1.16 | 1.46 | 0.30 |
| Level | A: Action Time (h) | B: Inoculation Quantity (%) | C: Temperature (°C) |
|---|---|---|---|
| −1 | 48 | 1 | 20 |
| 0 | 72 | 5.5 | 30 |
| 1 | 96 | 10 | 40 |
Disclaimer/Publisher’s Note: The statements, opinions and data contained in all publications are solely those of the individual author(s) and contributor(s) and not of MDPI and/or the editor(s). MDPI and/or the editor(s) disclaim responsibility for any injury to people or property resulting from any ideas, methods, instructions or products referred to in the content. |
© 2024 by the authors. Licensee MDPI, Basel, Switzerland. This article is an open access article distributed under the terms and conditions of the Creative Commons Attribution (CC BY) license (https://creativecommons.org/licenses/by/4.0/).
Share and Cite
Zhang, W.; Sun, C.; Wang, W.; Zhang, Z. Bioremediation of Aflatoxin B1 by Meyerozyma guilliermondii AF01 in Peanut Meal via Solid-State Fermentation. Toxins 2024, 16, 305. https://doi.org/10.3390/toxins16070305
Zhang W, Sun C, Wang W, Zhang Z. Bioremediation of Aflatoxin B1 by Meyerozyma guilliermondii AF01 in Peanut Meal via Solid-State Fermentation. Toxins. 2024; 16(7):305. https://doi.org/10.3390/toxins16070305
Chicago/Turabian StyleZhang, Wan, Changpo Sun, Wei Wang, and Zhongjie Zhang. 2024. "Bioremediation of Aflatoxin B1 by Meyerozyma guilliermondii AF01 in Peanut Meal via Solid-State Fermentation" Toxins 16, no. 7: 305. https://doi.org/10.3390/toxins16070305
APA StyleZhang, W., Sun, C., Wang, W., & Zhang, Z. (2024). Bioremediation of Aflatoxin B1 by Meyerozyma guilliermondii AF01 in Peanut Meal via Solid-State Fermentation. Toxins, 16(7), 305. https://doi.org/10.3390/toxins16070305

